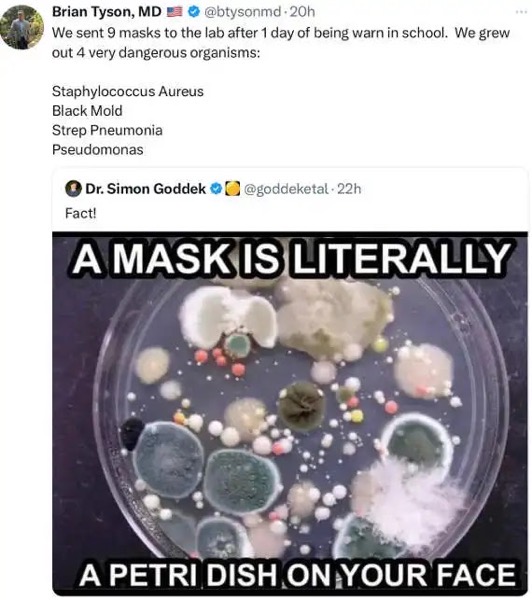

NOTE: Delayed a day due to holiday laziness, apologies for that.
Welcome to this week’s installment of our Wednesday meme feature, folks. Links to the “found via” sources will be attached to the specific MiQ’s (Memes in Question) whenever I can remember them, which likely won’t be very often. Only the first two memes will appear above the fold to save on bandwidth usage, since I assume not everybody who shows up at this here websty will want to see all of them. This intro will appear at the top of each week’s Memezapoppin’! post. Enjoy, funny-pitcher lovers.

- Entries
Fine batch they are, my fav being the mask/petri dish connection.
So five years along, and neither you nor the “doctor” (who couldn’t spell “worn” correctly) ever figured out that experiment is why surgical masks are worn in surgery, to keep the petri dish of shit inside, with the person generating them all, rather than spewing them around like Johnny Pestilence and Typhoid Mary? And that the whole purpose of those masks was to keep germs in, not out??
Tsk, tsk.
Do they even teach health science in schools any more?
I’m pretty sure he either graduated from medical school via internet correspondence from Bangladesh, or he’s a “doctor” of gender studies.
Dealer’s choice. 😛
That meme must be true, or they wouldn’t put it on the internet. I think I have a new Biff Tannen Award winner.
Jesus Christ. Four fucking years on, and you’re still defending the Covidiocy. Yes, Aesop, we remember how you cowered inside in your basement and excoriated everyone else who exercised a little bit of common fucking sense and lived their lives.
Here’s the thing. Surgery is different than daily life, and living one’s daily life does not require the same level of protection as someone performing surgery with a human body cut open in front of them.
Your “logic” is the same as all the white cat ladies who kept blabbering about how “I don’t wear the mask to protect me, I wear it to protect you.”
Sit this one out. You, and those like you, backed the biggest implementation of totalitarianism that our country has seen. You have lost all credibility to anyone with an IQ higher than that of a turnip.
“Do they even teach health science in schools any more?”
Apparently not in nursing school. If they did then perhaps you would know that:
1) Masks work quite well to trap bacteria
2) They wear them in surgery primarily to stop any bacteria from the doctors and nurses from getting into a wide open patient
3) A mask cannot stop airborne virus since the mask would have to be so fine the wearer could not breathe, the human lung does not have enough power to move air past that type of barrier. A powered mask is required.
That’s what actual education provides. Further observation after you leave “school” would provide data to analyze as it has done during the government engineered Virus scam – masks did nothing, 6 ft distancing did nothing, staying home did nothing. Why? Because old people are dying and the last step is the push over, flu, pneumonia, whatever, including the government engineered virus. It is nearly impossible to avoid contact with airborne virus without staying completely shut in, no deliveries, no visitors, zero outside contact – and even then air is still moving, delivering natures little beasts.
The most notable mark of intelligence is the ability to learn. None of the above is new, when will you figure this out?
As for the petri dish meme, quite appropriate, something else that intelligent people have figured out. All that requires is to remove a mask worn for a few minutes, and an electron microscope to see the virus and a regular microscope to see the bacteria. If you wish to culture them have at it. This isn’t even hard.
Oh, gee, if only I’d pointed out all that basic mask info five years ago online, and left it where it was easily checked.
Oh, wait…
https://raconteurreport.blogspot.com/2020/04/why-masks-and-gloves-will-and-wont-ever.html
Shit, I almost forget, I did all that.
Now, if only someone had looked into whether simple surgical masks made to contain large particles of outbound snot stopped COVID virus transmission in any form from blowing out, say maybe 6 feet away…
Oh, wait, that happened too.
https://www.nature.com/articles/s41591-020-0843-2
100x to 1000x less transmission, measured at 6′.
Holy shit. Almost like Pasteur was onto something.
Because viral nuclei don’t go flying out like dried cocoa powder, they get expelled in much larger vapor and mucus droplets that surgical masks contain quite easily, since ever.
Like I said, 5 years on, still not a clue on the most anti-scientific nonsense from the whole pandemic, but retarded memesters still want to sound smart, in a Dunning-Kruger sort of way.
Let it go.
https://imgflip.com/i/73mgu3
If those two internet idiots were “doctors” of anything remotely medical they would know you can’t infect yourself with the crap you blow out of your own snotlocker.
But 100:1 both of them would test positive for fecal bacteria on their own hands.
So the only risk those masks present is if strangers lick them after you wear and discard them.
In which case, anyone that stupid deserves what they get.
Infection risk to the wearers: 0%, forever.
Middle school health science FTW.
Also, COVID isn’t an airborne virus.
Words mean things, especially in epidemiology.
It’s a droplet-transmission vector.
And you don’t culture a virus on a Petri dish.
It requires a cellular host line or lines to see if it replicates.
All a petri dish culture proves is that people are little plague factories who don’t wash their ass-wiping hands on their best day, which is why 100% of McDonald’s touchscreen kiosks in the UK tested positive for fecal bacteria, and always will.
And why the problem is always stupid people doing stupid things, not things per se.
No, they are not “about 95-98% effective” at keeping virus from leaving the person and the mask. That is pure BS on your part. And yes, the damn government created virus is an AIRBORNE virus. Some of it will be in your spit, some will be in your shit, but your breathe will exhale the virus and you cannot stop that short of wearing a true powered filtration unit, or stop breathing.
The rest of what you say is just pure BS and theatre to cover up the truth –
You are flat out wrong about the ability of any mask to slow down the spread of airborne virus to an extent worth the problems wearing the mask do cause.
As for your complete bullshit about “So the only risk those masks present is if strangers lick them after you wear and discard them.”, do a proper culture of your own filth, then suck it in your lungs and see if has an effect. I’d say we would wait for the result but it’s likely you’ll be too damn sick to respond further.
“Also, COVID isn’t an airborne virus.”
While it is true that it can be carried as “droplets” this is true of all airborne virus. Nothing new there. Repeating the government line so as to create hysteria by forcing people to wear masks that do nothing is just more BS on your part. There is no proof that masks stop the transmission of government virus or flu virus. They spread, they spread where people wear masks and where they don’t. That is a fact.
That was proven by the fact that the virus spread regardless of the local protocol for masking.
In fact, even in the same local environment people studied transmission prior to the mask mandates and after them and there was no difference there either.
And these studies were done by May or June of 2020.
And all of this is summarized right there on the box.
Yep, the gold standard of masks states it will not stop virus transmission.
“How do you prepare the chicken?”
“We just tell ’em straight out they’re going to die.”
I lie to mine, just tell ’em they’re getting a bath in BBQ sauce.
I heard Mitch made his million$ on Hoyt-Clagwell stock…
Dog rings doorbell, starts barking like mad…
I might have one of those dogs…
Don’t we all.
You have two as I recall 🙂
The 19 year old beagle can’t hear well enough anymore, but the inherited dog (pure designer dog – half Jack Russel, half Chihuahua) certainly can and barks at the doorbell.
Yes, I have two ferocious killers (I keed – they’re sweethearts. They just don’t realize it)